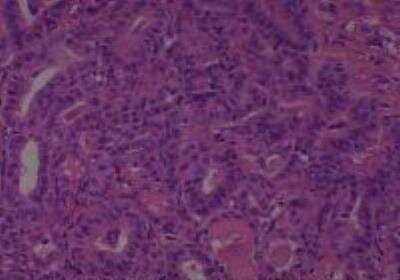
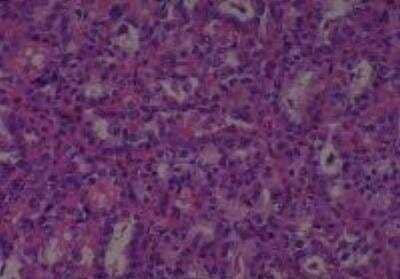

Human Thyroid Tissue MicroArray (Cancer)
Novus Biologicals, part of Bio-Techne | Catalog # NBP2-30317

Key Product Details
Species
Human
Applications
Immunohistochemistry
Product Summary for Human Thyroid Tissue MicroArray (Cancer)
Microarray Panel:
Thyroid cancer-normal
No. of samples: 59
No. of patients: 56
Core diameter: 2.0 mm
Format: Formalin Fixed
Section thickness: 4 micrometer
Please see manual for tissue information and location.
All tissues are fixed in 10% neutral buffered formalin for 12 to 24 hours, dehydrated with gradient ethanol, cleared with xylene, and embedded in paraffin. Then each slide is tested for immunohistochemistry on multiple antibodies including the p53 protein. Quality control is ensured as every tissue block is collected and arranged by certified pathologists, who used an identical process for their own research.
About 100,000 cells are included in each sample with 2 mm core diameter. Some slides may have less than 60 cores due to sample loss when obtaining multiple sections. Maximum number of missing cores in a slide is less than 10%.
Thyroid cancer-normal
No. of samples: 59
No. of patients: 56
Core diameter: 2.0 mm
Format: Formalin Fixed
Section thickness: 4 micrometer
Please see manual for tissue information and location.
All tissues are fixed in 10% neutral buffered formalin for 12 to 24 hours, dehydrated with gradient ethanol, cleared with xylene, and embedded in paraffin. Then each slide is tested for immunohistochemistry on multiple antibodies including the p53 protein. Quality control is ensured as every tissue block is collected and arranged by certified pathologists, who used an identical process for their own research.
About 100,000 cells are included in each sample with 2 mm core diameter. Some slides may have less than 60 cores due to sample loss when obtaining multiple sections. Maximum number of missing cores in a slide is less than 10%.
Product Specifications
Type
Tissue
Tissue Condition
Cancer
Scientific Data Images for Human Thyroid Tissue MicroArray (Cancer)
Hematoxylin & Eosin Stain: Human Thyroid Tissue MicroArray (Cancer) [NBP2-30317] - 01. Thyroid papillary carcinoma
Hematoxylin & Eosin Stain: Human Thyroid Tissue MicroArray (Cancer) [NBP2-30317] - 02. Thyroid Papillay Carinoma
Hematoxylin & Eosin Stain: Human Thyroid Tissue MicroArray (Cancer) [NBP2-30317] - Thyroid Papillary Carcinoma
Formulation, Preparation, and Storage
Concentration
Concentration is not relevant for this product. Please see the protocols for proper use of this product.
Shipping
The product is shipped with polar packs. Upon receipt, store it immediately at the temperature recommended below.
Storage
Store at 4C. Do not freeze.
Background: Thyroid
Additional Thyroid Products
Product Documents for Human Thyroid Tissue MicroArray (Cancer)
Product Specific Notices for Human Thyroid Tissue MicroArray (Cancer)
This product is for research use only and is not approved for use in humans or in clinical diagnosis. Tissue Micro Arrays are guaranteed for 1 year from date of receipt.
Loading...
Loading...
Loading...
Loading...